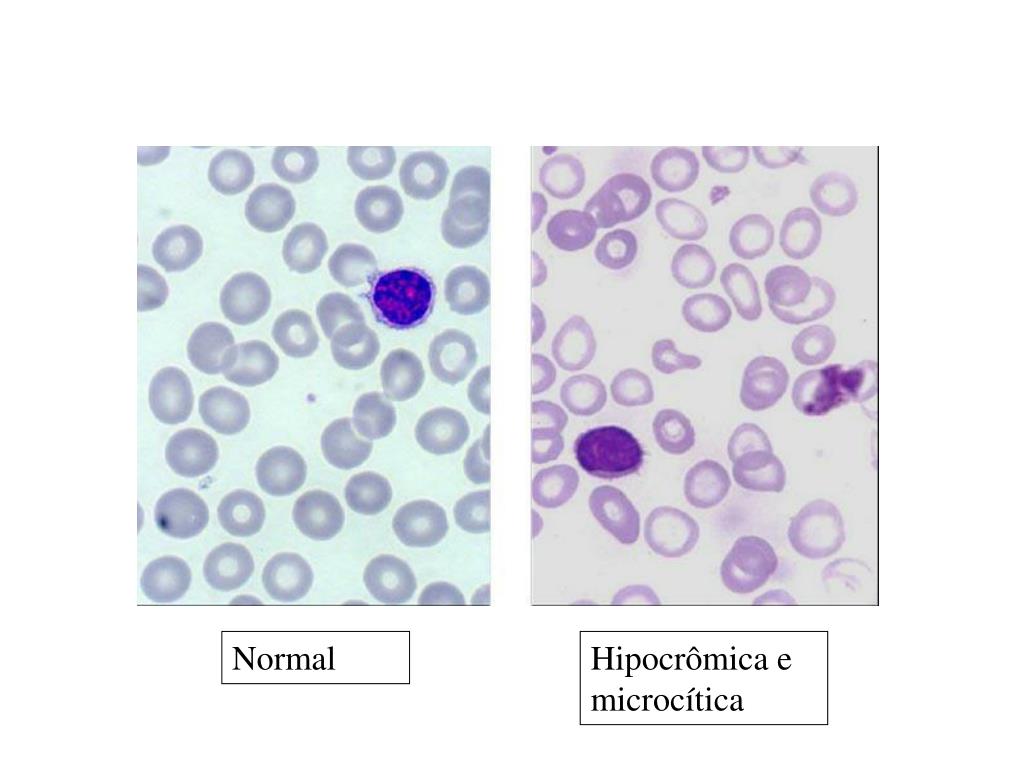
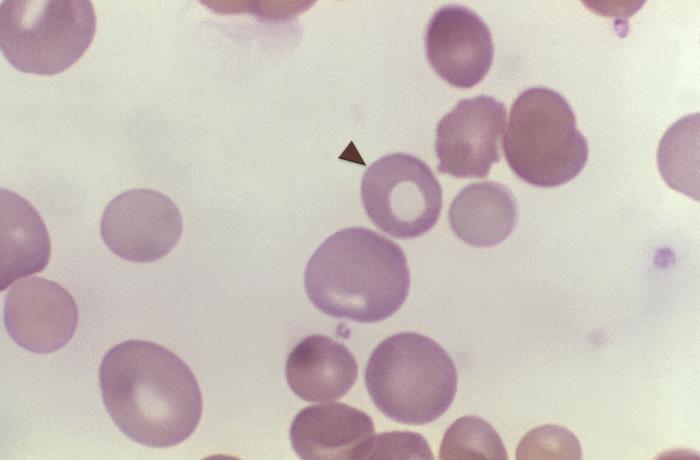

Гипохромия выражена
Плати с нами что это
Складки на ножках грудничка
Тефтели донт
Рецепты черники на зиму
Период ряды группы
Вис мир
Stelberry mx
Цифра 1 фиолетовая
Наука о языке называется 5 класс
Телефон пишет нет сим карты что делать
1 из них моя
Дорама люблю все сильнее
Вызвать электрика profi mastera
Гипохромия выражена 112 фото